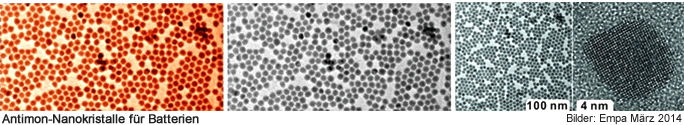

|
Neue Technologien: Alternative Speicherung |
 |
Energie Schweiz Speicherung - Übertragung |
 |
Energie Informationen |
 |
Beiträge zur Energie-Diskussion |
|
| Alternative Produktion, Übertragung und Speicherung von elektrischer Energie |
|
Fortschritt bei alternativen Stromspeichern |
 |
Antimon-Nanokristalle für Batterien
Forscherinnen und Forscher der Empa und der ETH Zürich haben erstmals einheitliche Antimon-Nanokristalle erzeugt. In Tests mit Laborbatterien können diese nicht nur sehr viele Lithium-, sondern auch Natriumionen speichern. Die Nanokristalle wären deshalb eine viel versprechende Alternative für künftige Elektrodenmaterialien in Batterien mit hoher Ladekapazität.
Die Jagd ist eröffnet. Und zwar auf neue Materialien für die nächste Generation von Batterien, die eines Tages Lithium-Ionen-Akkus ersetzen sollen. Diese liefern heutzutage für Smartphones, Laptops und viele weitere tragbare elektronische Geräte zuverlässig Strom. Doch die Elektromobilität und stationäre Energiespeicher verlangen nach mehr und leistungsfähigeren Batterien, und die damit einhergehende hohe Nachfrage nach Lithium könnte zu einem Engpass bei diesem Rohstoff führen. Gefordert sind deshalb Batterien, die konzeptionell mit Lithium-Ionen-Batterien identisch sind, aber auf Natriumionen basieren. Obwohl darüber bereits seit 20 Jahren geforscht wird, sind Materialien, die Natriumionen effizient speichern können, nach wie vor Mangelware.
Elektroden aus Antimon?
 |
| Auf der Suche nach alternativen Batteriematerialien ist das Team unter der Leitung von Empa-Forscher Maksym Kovalenko nun möglicherweise einen Schritt weitergekommen: Sie haben es als erste geschafft, gleichmässige Antimon-Nanokristalle zu synthetisieren. Diese bieten sich aufgrund ihrer besonderen Eigenschaften als Anodenmaterial an, und zwar sowohl für Lithium- als auch für Natriumionen. Die Resultate ihrer Studie wurden soeben in der Fachzeitschrift «Nano Letters» veröffentlicht.
Antimon galt schon lange als viel versprechendes Anodenmaterial für leistungsfähige Lithium-Ionen-Batterien, da dieses Halbmetall eine doppelt so hohe Ladekapazität wie das derzeit verwendete Graphit aufweist. |
|
Erste Studien zeigten dann auch, dass sich Antimon für wieder aufladbare Natrium- und Lithium-Ionen-Batterien eignen könnte, weil es beide Arten von Ionen speichern kann. Natrium ist eine mögliche günstigere Alternative zu Lithium, da es viel häufiger vorkommt und gleichmässiger auf der Erde verteilt ist.
Damit Antimon seine hohe Speicherfähigkeit auch «ausspielt», muss es indes in eine spezielle Form gebracht werden. Kovalenkos Team hat eine Methode entwickelt, um gleichmässige, monodisperse Antimon-Nanokristalle mit einer Grösse zwischen 10 und 20 Nanometer zu synthetisieren. Nanokristalle haben gegenüber grösseren Kristallen entscheidende Vorteile. Antimon ist beim Laden und Entladen der Ionen grossen Volumenveränderungen unterworfen. Bei Nanokristallen sind diese Volumenveränderungen reversibel und laufen schnell ab. «Normales» Antimon würde dabei hingegen brüchig. Ein weiterer wichtiger Vorteil: Antimon-Nanopartikel können mit leitfähigem Kohlenstoff-Füllmaterial vermischt werden. Das verhindert ein Verklumpen der Nanoteilchen.
Wunschkandidat für Anodenmaterial
Erste Labortests zeigten, dass Elektroden aus Antimon-Nanokristallen eine gleich hohe Leistung für beiden Ionenarten besitzen. Damit sind Antimon-Nanoteilchen besonders für den Einsatz in Natriumionen-Batterien geeignet, weil die derzeit besten Lithiumspeicher - Graphit und Silicium - mit Natrium nicht funktionieren.
Hochgradig gleichmässige Nanokristalle - nur gerade 10 Prozent oder weniger weichen in ihrer Grösse von der Durchschnittsgrösse der Partikel ab - erlaubten es den Forscher auch, das beste Verhältnis von Grösse zu Leistung zu ermitteln. Die höchste Leistung bieten Antimon-Nanokristalle von 20 Nanometer Grösse, fanden die Forscher heraus. Sind die Teilchen 10 Nanometer oder kleiner, wird das Verhältnis von Volumen zu Oberfläche ungünstig, und sie oxidieren rasch. Kristalle, die grösser als 100 Nanometer sind, werden hingegen durch die Volumenänderungen beim Laden und Entladen zerstört.
Eine weitere Erkenntnis ist, dass es für eine hohe Leistung gar nicht so sehr darauf ankomme, ultrauniforme Nanoteilchen in einer Elektrode einzusetzen. Die Forschenden fanden nämlich heraus, dass die Partikel zwischen 20 und 100 Nanometern gross sein können, ohne dass die Energiedichte oder die Entlade- und Laderaten darunter leiden. Antimon sei relativ «gutmütig», so Kovalenko. Andere Materialien, die die Chemiker untersuchten, sind diesbezüglich weniger tolerant. Steigt deren Partikelgrösse an, fallen die Leistungsparameter stark ab.
Teurere Alternative
Rückt damit eine Alternative zu heutigen Lithium-Ionen-Akkus in Griffweite? Kovalenko winkt ab. Noch ist die Herstellung einheitlicher Antimon-Nanokristalle in ausreichender Menge und Qualität zu teuer - obwohl das Verfahren an sich relativ einfach ist. «Insgesamt sind Batterien mit Natriumionen und Antimon-Nanokristallen als Anodenmaterial nur dann eine viel versprechende Alternative zu heutigen Lithium-Ionen-Akkus, wenn die Kosten für die Batterieherstellung und die Leistung des Stromspeichers vergleichbar sind», sagt Kovalenko.
Zurzeit arbeitet Kovalenkos Team zusammen mit einem Industriepartner daran, eine günstigere Synthesemethode zu finden. Bis eine Natriumionen-Batterie mit Antimonelektrode auf den Markt kommen könnte, dürfte es wohl noch mindestens zehn Jahre dauern, schätzt Kovalenko. Die Forschung dazu stehe erst am Anfang. «Aber andere Forschungsgruppen werden bald auf den Zug aufspringen», ist Kovalenko überzeugt.
(Text: Peter Rüegg, ETH Zürich)
| Quelle:
Text Empa - Materials Science & Technology - Eidg. Materialprüfungs-
und Forschungsanstalt, Mai 2014 |
 |
 |
 |
 |
 |
 |
| Lithium-Ionen-Batterien |
 |
| Eine heutige Lithium-Ionen-Batterie besteht aus zwei Elektroden - einer Kathode und einer Anode.
Die Anode besteht oft aus Graphit, die Kathode aus Metalloxiden wie Kobaltoxid. In diese Materialien nisten sich die Lithium-Ionen beim Laden oder Entladen ein.
Die beiden Elektroden sind durch eine Trennwand getrennt, die nur Lithium-Ionen durchlässt. |
|
Beim Entladen bewegen sich die Lithium-Ionen von der Anode zur Kathode. Die dabei frei werdenden Elektronen fliessen über den externen Stromkreis ebenfalls zur Kathode und treiben dadurch ein elektrisches Gerät an. Elektronen und Ionen treffen sich in der Kathode wieder. Beim Laden fliessen Ionen und Elektronen in die umgekehrte Richtung.
Damit eine Batterie gut und lange funktioniert, müssen sich die Ionen gut in die Elektrodenmaterialien hinein und aus diesen heraus bewegen können. Auch sollten sich Form und Grösse des Elektrodenmaterials durch die wiederkehrende Aufnahme und Abgabe der Ionen nicht wesentlich verändern. |
| Quelle:
Text Empa - Materials Science & Technology - Eidg. Materialprüfungs-
und Forschungsanstalt, Mai 2014 |
|
nach
oben
| Links |
 |
 |
 |
Externe Links |
|